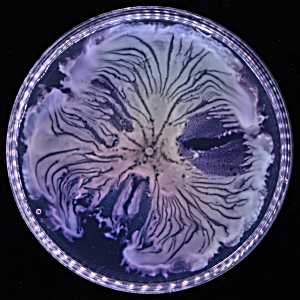

News & Events
News

The scientific research project, “Golden Air 黃金之風”, by a student research team from Stewards Pooi Kei College has won the Merit Award (Science Laboratory Secondary School) in the 7th Greater Bay Area STEAM Excellence Award 2025 (HKSAR). The project received help from Prof. Jianfang WANG’s group.
16 Oct 2025
16 Oct 2025
Read More
Dr. Weitao Lyu received NSFC Young Scientists Fund 2025 to support his project “THz Astronomical Polarimeter at Low Temperature”.
2 Sept 2025
02 Sep 2025
Read More
Dr. Matteo LULLI has been selected for the Young Scientist Award at the 34th International Conference on Discrete Simulations of Fluid Dynamics.
17 Jul 2025
Read More


Prof. Quan Li has been awarded the CUHK Outstanding Research Impact Award 2024-25
30 Jun 2025
Read More
Mr. Jianhao Wu (MPhil student) has been awarded the Third Prize on “Mathematics and Physics / Mechanics and Control Systems” track for the project “Save the small scale crisis in Milky Way with a blue tilted early universe model” in the Innovation and Entrepreneurship Competition 2025.
19 Jun 2025
Read More
Dr. Shiu-sing Tong has been awarded the Vice-Chancellor Exemplary Teaching Award 2024.
May 2025
17 Jun 2025
Read More
Prof. Xinhui Lu is awarded the Silver Medal for the project “GINDeX: Grazing – incidence Non – destructive X -ray testing system” at the 50th International Exhibition of Inventions Geneva (IEIG 2025).
14 Apr 2025
17 Apr 2025
Read More
Dr. Kenny L. S. Yip has been awarded the CC College General Education Outstanding Teaching Award 2024-25.
28 Mar 2025
14 Apr 2025
Read More
Dr. Shiu-sing Tong (on the left) has been awarded the Faculty Exemplary Teaching Award 2024 on 15 Feb 2025.
20 Mar 2025
22 Mar 2025
Read More
Prof. Yilin Wu and Prof. Renbin Yan are awarded funding from the “National Science Fund for Distinguished Young Scholars”, the highest level of young research talent development program under the foundation.
03 Jan 2025
Read More

CUHK Vice-Chancellor Early Career Professorship Scheme welcomes applications from scholars and scientists in any discipline. Candidates with research works related to the mentioned research areas, even though loosely related, are very welcome to apply.
12 Aug 2024
Read More
Prof. Xinhui Lu has been awarded the title of “RGC Research Fellow” under the 2024-25 Research Grants Council (RGC) Research Fellow Scheme in recognition of her distinguished research achievements.
11 Jul 2024
Read More
Our MSc student Mr. Pak Gei Yeung (left) obtained a championship in the Hong Kong Electronics Project Competition 2024 (Tertiary Education Category). The awarded project title is “Unclonable electronic device for authentication of product and anti-counterfeit”.
17 Jun 2024
Read More
Our research teams led by Prof. Quan Li, Prof. Daniel Ong and Prof. Lei Xu have been recognized and honoured with three medals at the 49th International Exhibition of Inventions Geneva!
23 Apr 2023
23 Apr 2024
Read More
Dr. Marco Y. H. Lai has been awarded the Faculty Exemplary Teaching Award 2023
23 Apr 2024
23 Apr 2024
Read More
Prof. Xinhui Lu and Prof. Luis Flores Castillo have been awarded the Departmental Teaching Award 2023.
12 Apr 2024
12 Apr 2024
Read More
Prof. Yilin Wu’s team discovers new mechanism for spontaneous large-scale pattern formation in living matter. This study has recently been published in the scientific journal Nature.
27 Mar 2024
27 Mar 2024
Read More
Prof. Kenny C. Y. Ng has been awarded RMB2 million research funding from the Excellent Young Scientists Fund (Hong Kong and Macao) 2023, to support his research in Hong Kong for a maximum of three years.
27 Sept 2023
27 Sep 2023
Read More
Prof. Renbao Liu has been awarded the appointment of “Choh-Ming Li Professor of Physics” for a term of 5 years, in recognition of his outstanding academic achievements.
15 Aug 2023
15 Aug 2023
Read More
Prof. Yilin Wu has been awarded the Xplorer Prize 2023 (from the Tencent Foundation) in the field of advanced interdisciplinary studies
20 Jul 2023
Read More
The research team led by Professor Liu Renbao has been awarded a grant of more than HK$7 million to carry out research on “Diamond-based Multi-modal Quantum Sensing of Nanomagnetism”
18 Jul 2023
20 Jul 2023
Read More
Prof. Zhengcheng Gu selected as the RGC Research Fellow 2023/24 and obtained ~HK$5 million in sponsorship of the fellowship.
19 Jul 2023
Read More
Mr. LAI Lok Kan (Physics Year 3) has been awarded the HSBC Hong Kong Scholarship 2022/23.
18 Jul 2023
18 Jul 2023
Read More
Mr. LAI Lok Kan (Physics Year 3) has been awarded the Innovation and Technology Scholarship 2023.
14 Jun 2023
14 Jun 2023
Read More
中大超算隊(包括物理系本科生陳凱文、盧若晞和戴傳禧)於第十屆ASC世界大學生超級計算機競賽的現場競賽中獲得超級團隊獎、及於綫上競賽中獲得冠軍和應用創新獎。競賽共有全球300餘支高校代表隊報名參加,經過預賽選拔有24支隊伍晋級總决賽,主要比拼AI語言大模型等前沿科學研究應用。
15 May 2023
Read More
Discovery: Decoding Zeeman measurements, the holy grail of cloud B-field observations
Dr. Zhuo Cao (PhD in PHY) and Prof. Hua-bai Li published a paper “Turbulence in Zeeman Measurements from Molecular Clouds” in The Astrophysical Journal Letters that resolves a decade-old mystery about molecular cloud B-fields.
25 Apr 2023
Read More
Orientation-Dependent Interaction between the Magnetic Plasmons in Gold Nanocups and the Excitons in WS
Dr. Ruoqi Ai (PhD in MSE), Mr. Xinyue Xia (PhD student), Dr. Han Zhang (PhD in MSE), Mr. Ka Kit Chui (MPhil student) and Prof. Jianfang Wang recently published an article in ACS Nano.
13 Apr 2023
Read More
Accretion-induced Collapse of Dark Matter-admixed Rotating White Dwarfs: Dynamics and Gravitational-wave Signals
MPhil graduate Ho Sang Chan and Prof. Chu at CUHK, together with Prof. Shing Chi Leung at the SUNY Polytechnic Institute, recently published an article in The Astrophysical Journal. Their research utilized computer simulations to study the accretion-induced collapse of dark matter-admixed white dwarfs and predicted the gravitational-wave signatures of the presence of dark matter.
06 Apr 2023
Read More
Expansion dynamics of a shell-shaped Bose-Einstein condensate
Dr. Fan Jia (PhD in PHY), Mr. Zerong Huang (PhD student), Mr. Rongzi Zhou (PhD student), Prof. Yangqian Yan, Prof. Dajun Wang et al. published an article in Physical Review Letters.
03 Apr 2023
Read More
Discovery: Swimming bacteria stay away from solid walls in polymeric environments
Dr. Song Liu (PhD in PHY), Prof. Yilin Wu et al. published an article “Reduced surface accumulation of swimming bacteria in viscoelastic polymer fluids” in Proceedings of the National Academy of Sciences (PNAS).
28 Mar 2023
Read More
Discovery: A new form of active matter – living active solids – shows autonomous waves and global motion
Dr. Haoran Xu (PhD in PHY), Prof. Yilin Wu et al. published an article “Autonomous waves and global motion modes in living active solids” in Nature Physics.
28 Mar 2023
Read More
Discovery: Nodeless Superconductivity with and without Time Reversal Symmetry Breaking
Dr. Wei Zhang (PhD in PHY, currently a postdoc at our department), Prof. Kwing To Lai, Prof. Swee K. Goh and their team published an article “Nodeless Superconductivity in Kagome Metal CsV3Sb5 with and without Time Reversal Symmetry Breaking” in Nano Letters. The team used hydrostatic pressure to tune the phase transition temperature of the charge-density-wave phase, which has been shown to break the time-reversal symmetry. Using critical current measurements and the impurities effect, they further explore the superconducting state, allowing them to conclude that the superconducting gap does not possess any node regardless of the presence of the time-reversal symmetry.
22 Feb 2023
Read More
Dr. Jingren Zhou, PhD in Physics, has been selected for the Science Faculty Postgraduate Research Output Award 2021.
21 Feb 2023
Read More
Prof. Swee Kuan Goh has been selected for the Science Faculty Young Researcher Award 2021.
21 Feb 2023
Read More
Prof. Lei Xu’s team takes magic of invisibility cloak and creates a mega device – potential applications span novel cell culture and drug delivery. The findings have been published in Proceedings of the National Academy of Sciences (PNAS)
01 Feb 2023
Read More
Prof. Xinhui Lu received the CRF 2022/23 Young Collaboration Research Grant (YCRG) to support her project “Fundamental-studies-guided growing of high-quality, mechanically stable, reduced-dimensional perovskites for scalable flexible optoelectronic devices”.
30 Jan 2023
Read More
Prof. Renbao Liu received the NSFC/RGC Collaborative Research Scheme fund to support his project “Superradiant time-crystal maser and applications in quantum metrology”.
30 Jan 2023
Read More
Prof. Renbao Liu selected as 2022 New Cornerstone Investigator by Tencent. The New Cornerstone Investigator grant will support Prof. Liu to establish a theory of quantum many-body lasers.
18 Jan 2023
Read More
Prof. Yilin Wu’s team discovers a new surprising form of bacterial teamwork that builds “acterial canals” to transport materials over long distances. The findings have been published in eLife
22 Dec 2022
Read More
Prof. Quan Li has been selected for the Croucher Senior Research Fellowships 2023-2024, for her excellent research achievements.
09 Dec 2022
Read More
Mr. Billy K. K. Lee (MPhil in PHY) et al. published an article “An exploration of the properties of cluster profiles for the thermal and kinetic Sunyaev–Zel’dovich effects” in Monthly Notices of the Royal Astronomical Society.
07 Nov 2022
Read More
Professors Otto Hannuksela, Tjonnie Li and Ren-Bao Liu have received the China Top Cited Paper Awards by the Institute of Physics (IOP) Publishing for their research papers. IOP Publishing selected papers from across the entire IOP Publishing journal portfolio within the past three years (2019-21) and recognized those were the top one per cent of most cited papers in different areas.
02 Nov 2022
Read More
Prof. Yangqian Yan received the NSFC Young Scientists Fund 2022 to support his project “Equation of state and thermodynamic properties of the unitary Fermi gas”.
06 Oct 2022
Read More
Prof. Zheng-Cheng Gu et al. published an article “Emergence of Gapless Quantum Spin Liquid from Deconfined Quantum Critical Point” in Physical Review X.
20 Sep 2022
Read More
Prof. Ming Chung Chu has been awarded the appointment of “Choh-Ming Li Professor of Physics” for a term of 5 years, in recognition of his outstanding academic achievements.
25 Aug 2022
Read More
Faces of CUHK Science: Digging Deep to Discover New Destinations – YEUNG Chun Yat Frankie (PHY 2021, CCC)Faces of CUHK Science: Digging Deep to Discover New Destinations – YEUNG Chun Yat Frankie (PHY 2021, CCC)
[Repost by kind permission of Science Faculty.]
17 Jun 2022
Read More
A Hong Kong team led by Prof. Ming Chung Chu contributed to the Daya Bay reactor neutrino experiment producing the most precise neutrino measurement ever.
09 Jun 2022
Read More
Mr. Joseph Gais (MPhil in PHY), Eungwang Seo (PhD student in PHY), Prof. Tjonnie G.F. Li et al. published an article “Inferring the Intermediate-mass Black Hole Number Density from Gravitational-wave Lensing Statistics” in The Astrophysical Journal Letters.
09 Jun 2022
Read More
Mr. Junyu Lin (PhD student in PHY), Dr. Junyu He (PhD in PHY), Prof. Dajun Wang et al. published an article “Seconds-Scale Coherence on Nuclear Spin Transitions of Ultracold Polar Molecules in 3D Optical Lattices” in Physical Review Letters.
01 Jun 2022
Read More
Event Horizon Telescope (Dr. Po Kin Leung and Mr. Tin Lok Chan (Physics/Yr 4) are in the collaboration) reveals the first image of the black hole at the Milky Way’s heart.
26 May 2022
Read More
Mr. Jack Yat-long Kwok (Physics/Yr 4) has been selected for the 2022 Joseph Needham PhD Fellowship tenable at the University of Cambridge.
25 May 2022
Read More
Ms. Alena Boyko (Physics/Yr 4) was awarded the Endeavour Merit Award 2020/21 and Hong Kong, China – Asia-Pacific Economic Cooperation Scholarship by the Education Bureau.V
10 May 2022
Read More
Prof. Ren-Bao Liu, Prof. Quan Li et al. published an article “Revealing Capillarity in AFM Indentation of Cells by NanodiamondBased Nonlocal Deformation Sensing” in Nano Letters.
04 May 2022
Read More
Prof. Zhengcheng Gu has been selected for the CUHK Research Excellence Award 2021-22.
03 May 2022
Read More
Prof. Renbao Liu has been selected for the RGC Senior Research Fellow Scheme 2022/23 and received grant to support his project “Quantum Nonlinear Spectroscopy – A New Paradigm of Quantum Sensing”.
02 May 2022
Read More

Mr. Ken K. Y. Ng (PHY 2017, CCC) received the Croucher Scholarship 2022-23. [Photo caption: Ken (right) and his advisor from his thesis defense]
20 Apr 2022
Read More
Mr. Leif Lui (Physics/Yr 2) received the Innovation and Technology Scholarship 2022.
17 Apr 2022
Read More
Mr. Shun-Sun Luk (MPhil in PHY), Prof. Hua-bai Li et al. published an article “Velocity Anisotropy in Self-gravitating Molecular Clouds. II. Observation” in The Astrophysical Journal.
04 Apr 2022
Read More
Ms. Yao Lu (PhD student in MSE), Ms. Shiu Hei Lam (MPhil in PHY), Prof. Jianfang Wang et al. published an article “All-State Switching of the Mie Resonance of Conductive Polyaniline Nanospheres” in Nano Letters.
27 Jan 2022
Read More
Prof. Renbin YAN’s team releases largest-ever collection of 3D maps of nearby galaxies and the largest-ever stellar spectral library.
[Prof. Renbin Yan’s website]
17 Jan 2022
Read More
Prof. Renbao Liu was selected for the 2022 Willis E. Lamb Award for Laser Science and Quantum Optics, for his outstanding contributions to the field.
30 Dec 2021
Read More
Mr. Yat To Tang (MPhil student in PHY) and Dr. Lap Ming Lin published an article “Neutron star oscillations in pseudo-Newtonian gravity” in Monthly Notices of the Royal Astronomical Society.
20 Dec 2021
Read More
The scientific research project, “Gold Nanorod Time Temperature Indicator”, by three students from Hong Kong Baptist University Affiliated School Wong Kam Fai Secondary and Primary School has been shortlisted as one of the “Top 120 Projects” in the Hong Kong Science Fair 2021-22 and won the Merit Award (Senior Secondary Division). The project received help from Prof. Jianfang WANG’s group.
17 Dec 2021
Read More
Prof. Emily S. C. Ching has been selected for the Vice-Chancellor’s Exemplary Teaching Award 2021.
17 Dec 2021
Read More
The scientific research project, “GoldIn”, by three students from Hong Kong Baptist University Affiliated School Wong Kam Fai Secondary and Primary School has awarded the First Prize of the 24th Hong Kong Youth Science and Technology Innovation Competition in the Secondary School Research and Invention (Senior Secondary) Biology and Health category. The project received help from Prof. Jianfang WANG’s group.
15 Dec 2021
Read More
Dr. Billy K. K. Lee, Prof. Ming Chung Chu and Dr. Lap Ming Lin published an article “Could the GW190814 Secondary Component Be a Bosonic Dark Matter Admixed Compact Star?” in Astrophysical Journal.
03 Dec 2021
Read More
Science through the Lens – Mr. Tse Shing Him Samuel (Physics/Yr 2)
[Repost by kind permission of Chung Chi College. The article was originally published in Chung Chi Campus Newsletter.]
20 Nov 2021
Read More
Prof. Emily S. C. Ching has been selected for the Faculty Exemplary Teaching Award 2021.
17 Nov 2021
Read More
Dr. Lap Ming Lin and Prof. Daniel Ong have been selected for the Physics Department Teaching Award 2021 for their outstanding contributions to teaching in 2021.
Dr. Lin’s teaching has been well received by more than 300 students in physics and general education courses. Prof. Ong revamped the undergraduate laboratory courses by introducing new contents in experimental physics.
15 Nov 2021
Read More
Prof. Lei Xu’s group discovers a novel method to adjust the elasticity of material for achieving smart elastic metamaterials.
04 Nov 2021
Read More
Dr. Jianyu Xie (PhD in MSE), Prof. Kwing To Lai, Prof. Swee K. Goh et al. published an article “Fragile pressure-induced magnetism in FeSe superconductors with a thickness reduction” in Nano Letters.
29 Oct 2021
Read More
Mr. Xinxin Xia (PhD student in MSE), Dr. Tsz-Ki Lau (PhD in PHY), Prof. Xinhui Lu et al. published an article “Uncovering the out-of-plane nanomorphology of organic photovoltaic bulk heterojunction by GTSAXS” in Nature Communications.
28 Oct 2021
Read More
Prof. Renbao Liu was elected as a Fellow Member of Optica for 2022, for original contributions to nonlinear and quantum optics and their applications in quantum information technologies.
18 Oct 2021
Read More

Dr. Haoyuan Bai (PhD in MSE), Ms. Shiu Hei Lam (MPhil in PHY), Prof. Jianfang Wang et al. published an article “A Schottky-Barrier-Free Plasmonic Semiconductor Photocatalyst for Nitrogen Fixation in a “One-Stone-Two-Birds” Manner” in Advanced Materials.
16 Oct 2021
Read More
Dr. Jianhua Yang (PhD in MSE), Dr. Jiapeng Zheng (PhD in MSE), Prof. Jianfang Wang et al. published an article “Plasmon-Enhanced, Self-Traced Nanomotors on the Surface of Silicon” in Angewandte Chemie International Edition.
18 Sep 2021
Read More
Dr. Patrick C.K. Cheong (PhD in PHY), Mr. Alan T.L. Lam (MPhil in PHY), Prof. Tjonnie G.F. Li et al. published an article “Gmunu: paralleled, grid-adaptive, general-relativistic magnetohydrodynamics in curvilinear geometries in dynamical space-time” in Monthly Notices of the Royal Astronomical Society.
16 Sep 2021
Read More
Prof. Xinhui Lu received China’s Excellent Young Scientists Fund 2021 which supports her research project on “X-ray scattering Based Microstructure Studies of Photovoltaic Materials”.
22 Aug 2021
Read More
Prof. Xinhui Lu published an article “Unveiling the crystalline packing of Y6 in thin films by thermally induced “backbone-on” orientation”.
13 Jul 2021
Read More
Miss Sonja On To Choi (Year 4 student) was awarded the Innovation and Technology Scholarship 2021.
23 Jun 2021
Read More
Prof. Jianfang Wang et al. published an article “How to Utilize Excited Plasmon Energy Efficiently” in ACS Nano.
17 Jun 2021
Read More
Prof. Keqing Xia was elected as the Academician of Chinese Academy of Sciences 2021.
17 Jun 2021
Read More
Prof. Jianfang Wang received the ANR/RGC Joint Research Scheme grant to support his project “Electrically-Excited Chiral Plasmonic Nano Cavities”
[What is ANR/RGC Joint Research Scheme]
17 May 2021
Read More
Dr. Qin Minchao, PhD in Materials Science and Engineering, has been selected for the CUHK Young Scholars Thesis Award 2020
07 Apr 2021
Read More
Physics alumnus, Mr. HO Chun Yan received Outstanding Alumni Service Award (Career Development) 2021 from Science Faculty
05 Apr 2021
Read More
An interview with physics alumnus: Mr. SHIU Man Lai, Professor of University of Wisconsin-Madison (from CU Alumni Magazine No. 107)
01 Apr 2021
Read More
Mr. Junyu Lin (PhD student in PHY), Dr. Junyu He (PhD in PHY), Prof. Dajun Wang et al. published an article “Probing Photoinduced Two-Body Loss of Ultracold Nonreactive Bosonic
02 Mar 2021
Read More
An international team of scientists including our physics student discovered the “Heaviest Black Hole Collision” might be a Boson star merger.
25 Feb 2021
Read More
Prof. Quan Li was selected for Fellow of the Royal Society of Chemistry in April 2021.
17 Feb 2021
Read More
We discovered new route to active matter self-organisation, provides new directions on fabricating self-driven devices and microbial physiology.
04 Feb 2021
Read More
